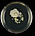
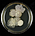

Nacht der Wissenschaft 2019
Volles Haus zur 11. Nacht der Wissenschaften

Mehr als zweitausend Menschen besuchten die Nacht der Wissenschaften der Hochschule Mittweida am 21. Juni. Damit wurde der Besucherrekord der vorangegangenen Jahre gebrochen. Mit den über 70 Experimenten, kreativen Angeboten und Vorträgen bot die Hochschule den Besuchern von 18 bis 0 Uhr ein interdisziplinäres Programm an. Schüler und frischgebackene Abiturienten konnten außerdem die Chance nutzen, sich mit den studentischen Helfern über das Studium in Mittweida zu unterhalten.
Auch die Fachgruppe Biotechnologie und Chemie stellte ein breites Programm zusammen: Zum Nachdenken regte Prof. Dr. Röbbe Wünschiers im „Café- Macht der Wissenschaft“ gemeinsam mit Soziologin Prof. Dr. Gudrun Ehlert an. Sie diskutierten zusammen mit den Gästen unter anderen über Gentechnik und Designer-Babies. Auf der „Wissenschaftsmeile“ zwischen Haus 3 und Haus 6 prüfte Frau Prof. Petra Radehaus mit einem Bilderquiz das Mikroben-Wissen der großen und kleinen Besucher.
Weiter ging es in der „Biobox“ (Haus 29c). Hier konnte jeder seine eigene DNA aus seinen Mundschleimhautzellen extrahieren und später in einer Halskette mit nach Hause nehmen. Über 250 Gäste nahmen dieses Highlight war. Für die Wartezeit zwischen den Inkubationen wurde auch gesorgt: mit durch flüssigen Stickstoff hergestellten Eis und selbstgemachten Shlushies im Reagenzröhrchen. Für einen genaueren Blick auf Pollen im Frühstückshonig standen verschiedene Honigproben im Mikroskopieraum bereit. Nebenan konnten die Besucher Abdrücke von ihrer Hautflora auf einer Platte erstellen. Den kann man sich nun anschauen (siehe unten) und bestaunen wie viele Bakterien gewachsen sind. Gestaunt haben auch viele Kinder als nach dem Einlaminieren ein vorher noch liebevoll mit thermochromen Farben ausgemaltes Pantoffeltierchen plötzlich seine Farbe verlor.